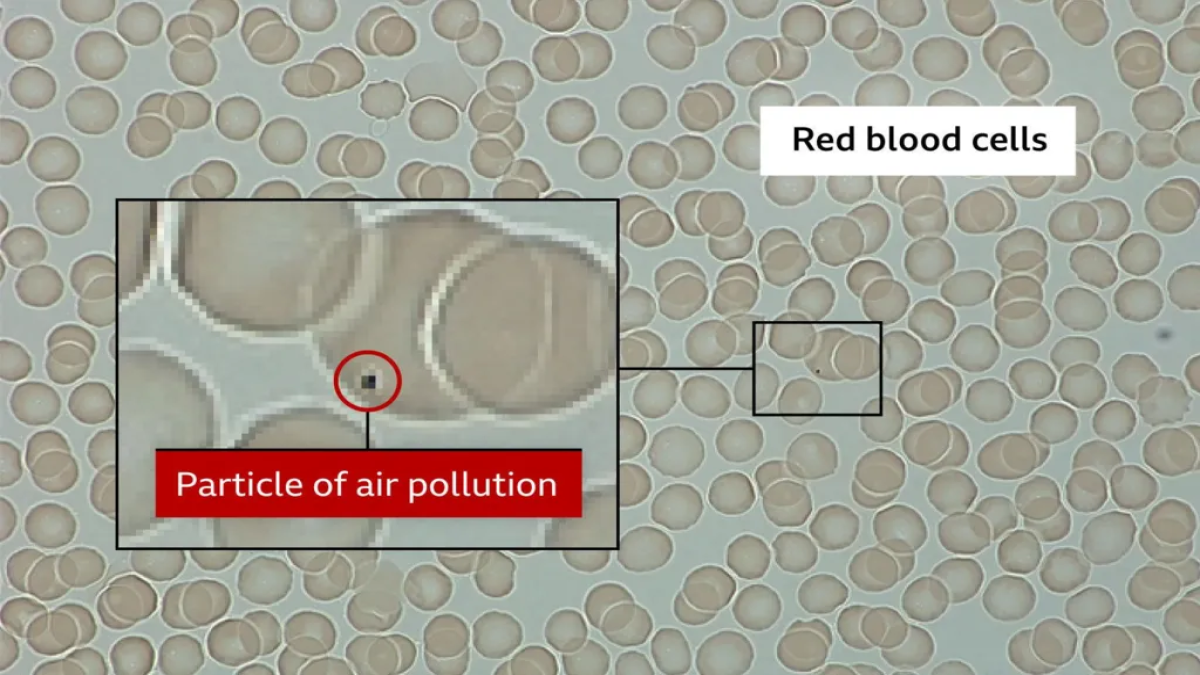
gorsel-2026-02-10-134752675.png

Londra’nın en yoğun caddelerinden birinde gerçekleştirilen deneyde Gallagher, dört şeritli trafiğin yanında sadece 10 dakika nefes aldı.
Queen Mary Üniversitesi'nden Prof. Jonathan Grigg liderliğinde yürütülen çalışmada, çoğu kişinin hava kirliliğinin burun ve ağız yoluyla filtrelendiği ya da akciğerlerde hapsolduğu yönündeki inancının yanlış olduğu ortaya kondu.
Deneyden hemen sonra laboratuvarda yapılan kan analizinde, Gallagher'ın tertemiz olması gereken kırmızı kan hücrelerinin üzerinde "minyatür kömür parçalarını" andıran siyah noktalar görüldü. PM 2.5 olarak adlandırılan ve 2,5 mikrometreden küçük olan bu partiküllerin, akciğer zarını aşarak doğrudan kan dolaşımına sızdığı mikroskop altında net bir şekilde kanıtlandı.

VÜCUTTA 80 MİLYON KİRLİ KAN HÜCRESİ DOLAŞIYOR OLABİLİR
Araştırmacı Dr. Norrice Liu, onlarca gönüllü üzerinde yaptığı çalışmalarda ortalama her 2-3 bin kırmızı kan hücresinden birinin bu kirlilik partiküllerini taşıdığını belirtti.
Bir yetişkinin vücudundaki 5 litre kan baz alındığında, yaklaşık 80 milyon kan hücresinin hava kirliliğini tüm organlara taşıdığı tahmin ediliyor. Prof. Grigg, bu partiküllerin vücuttan atılmadığını, aksine kan damarlarının duvarlarından sızarak hayati organlara yerleştiğini ifade etti.
Bu bulgu, hava kirliliğinin sadece akciğer hastalıklarıyla değil; neden anne karnındaki bebeklerden beyin sağlığına kadar vücudun her noktasına zarar verdiğini, plasentada neden siyah karbon birikintilerine rastlandığını bilimsel olarak açıklıyor.
HAVA KİRLİLİĞİ KALP KRİZİNDEN DEMANSA KADAR PEK ÇOK HASTALIĞI TETİKLİYOR
Araştırma, kirli havanın vücutta oluşturduğu kronik enflamasyonun (iltihaplanma) kalp krizi ve felç riskini nasıl artırdığını ortaya koydu.
İngiltere’deki her 10 akciğer kanserinden birinin hava kirliliği kaynaklı olduğu tahmin edilirken, Sir Stephen Holgate kirliliğin beyindeki toksik protein plaklarının oluşumunu hızlandırarak demans sürecini tetiklediğine dikkat çekti.

Holgate özellikle bebek arabasındaki çocukların egzoz borusu hizasında olmaları nedeniyle daha büyük risk altında olduğunu vurguladı. Bireysel olarak ara sokaklardan yürümek veya kalabalık yollarda maske takmak bir çözüm olsa da Prof. Grigg, asıl çözümün politika yapıcıların emisyon standartlarını düşürmesi olduğunun altını çizdi.
